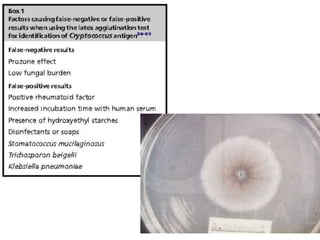

Este documento resume las principales neuroinfecciones que afectan a pacientes con VIH. Menciona que la demencia por VIH es una enfermedad degenerativa causada por cambios atroficos en el cerebro. También describe enfermedades como la leucoencefalopatía multifocal progresiva, toxoplasmosis, citomegalovirus, criptococosis, aspergilosis y tuberculosis, detallando sus características clínicas, diagnóstico e imagenología. Finalmente, hace énfasis en la necesidad de un diagnóstico y tratamiento